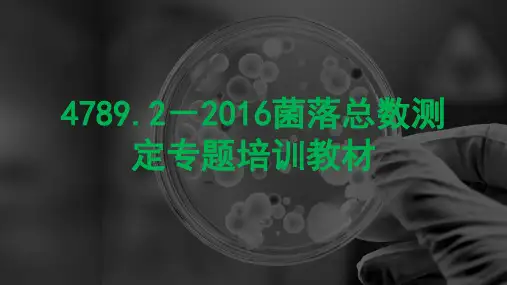

GB 4789.2-94 菌落总数测定
- 格式:pdf
- 大小:136.47 KB
- 文档页数:4

菌落总数检测标准
菌落总数检测是一种常见的微生指标检测方法用于评估食品、饮用水、医疗器械等物品中的微生物污染情况。
检测的菌落总一般采用生物计数法,即推测细菌总数的检验方法。
不同国家和地区可能有不同的标准和规定,但通常微生物指标检测标准的结构都是相对类似的,包括菌落总数、大肠埃希氏菌、霉菌、酵母菌等项目。
这些标准涉及了食品安全、饮用水卫生、医疗器械清洁等方面。
以下是一些常见的菌落总数检测标准:
1. 食品行业:根据《食品安全国家标准食品微生物学检验菌落总数的测定GB 4789.2-2016》,菌落总数检测的标准上限值因不同食品类别而有所不同。
2. 饮用水行业:根据《生活饮用水卫生标准GB 5749-2006》,每毫升饮用水中的菌落总数应低于100个。
3. 医疗器械清洁行业:医用器械清洁标准如ISO 15883等对菌落总数也有相关的规定。
需要注意的是,具体标准和检测方法可能因国家、行业、用途等
而异,建议根据具体情况查询相关标准以获取最准确的信息。


菌落总数国标简介菌落总数是一种常见的微生物分析方法,用于评价食品、水源、空气等样品中微生物的污染情况。
通过统计菌落总数,可以了解样品中存在的细菌、真菌和其他微生物的数量,进而进行适当的卫生措施和监测。
在国际上,每个国家或地区都有自己的菌落总数标准。
本文主要介绍中国的菌落总数国标,即GB 4789.2-2016《食品安全国家标准食品微生物学检验检验菌落总数》。
GB 4789.2-2016GB 4789.2-2016是中国食品安全领域的一个国家标准,于2016年开始实施。
它规定了食品检验中菌落总数的检测方法及其评估标准。
适用范围GB 4789.2-2016适用于各类食品中菌落总数的检测,包括肉、禽、水产品、豆制品、果蔬制品等。
该标准主要用于食品生产企业的自检和卫生监督机构的抽检。
检测方法GB 4789.2-2016规定了两种菌落总数的检测方法,即总数平板法和膜过滤法。
以下是这两种方法的简要步骤:总数平板法1.准备含有适宜营养成分的琼脂平板。
2.将样品适当稀释,然后分别在琼脂平板上均匀涂布。
3.将涂布好的平板培养在适当的温度下,通常为30°C,时间为48小时。
4.统计菌落总数,并计算出菌落形成单位(CFU)。
膜过滤法1.准备含有适宜营养成分的琼脂膜。
2.将样品通过膜过滤器,将样品中的微生物过滤到琼脂膜上。
3.将琼脂膜放置在含有适宜营养成分的平板上,然后培养在适当的温度下,通常为30°C,时间为48小时。
4.统计菌落总数,并计算出菌落形成单位(CFU)。
评估标准GB 4789.2-2016根据菌落总数的大小,将食品分为三个级别:一级、二级和三级。
以下是各级别的评价标准:•一级标准:CFU/g或CFU/mL小于100。
•二级标准:CFU/g或CFU/mL介于100到100,000之间。
•三级标准:CFU/g或CFU/mL大于100,000。
根据菌落总数的级别,可以判断食品的卫生状况和微生物污染的程度。

食用保健品执行标准号GB2760-1996食品添加剂使用卫生标准GB4789.2-94食品卫生微生物学检验菌落总数测定GB4789.3-94食品卫生微生物学检验大肠菌群测定GB4789.4-94食品卫生微生物学检测沙门氏菌检验GB4789.5-94食品卫生微生物学检验志贺氏菌检验GB4789.10-94食品卫生微生物学检验金黄色葡萄球菌检验GB4789.11-94食品卫生微生物学检验溶血性链球菌检测GB4789.15_94食品卫生微生物学检验霉菌和酵母计数1、GMP:即工厂质量环境认证。
要求工厂方圆300公里以内没有任何的污染源才能接受认证。
加拿大素有“地球北肺”之称(“南肺”是巴西),盖尔玛产品全都出厂于加拿大,从根本上保证了盖尔玛产品的生产工厂环境的优越。
2、FDA:是美国国家食品药品管理局的英文缩写,FDA的认证是世界上所有的保健品、药品还有营养食品通往欧洲和北美市场销售的一个通行证(最低门槛),FDA的认证需要2-3万欧洲人次,3-7年的临床检验,花费约3.5亿美元的成本,通过143项关键检测点程序才能获得认证,盖尔玛的所有产品全部都超越了FDA的认证标准。
同时也全部超过加拿大联邦健康和福利部185项关键检控点的标准。
3、DIN是世界医药组织认证的药物识别代码,它相当于药品身份证,有了它,就表明企业所生产的产品具有药品的功效却没有药品的毒副作用。
盖尔玛每一款产品包装上都标有DIN的代码。
4、OTC是非处方用药的认证,就是无需医生开处方的药品。
这就确认了盖尔玛的产品是非处方的,但又安全、功效好的保健品。
5、GLP是无需临床检验认证。
一般健康生活用品从宣传到上市要通过很多包括FDA在内的各项认证,而且要花费很长时间,有可能上市就已经落后了,而盖尔玛的产品是无须临床检验的,直接可以上市,大大超越了同类企业。


细菌菌落总数卫生标准细菌菌落总数是指在一定面积或容积内,培养基上生长出的可见的细菌菌落的总数。
细菌菌落总数是衡量环境卫生状况的重要指标之一,也是评价食品、饮用水、医疗器械等卫生质量的重要依据。
细菌菌落总数的高低直接关系到人们的健康和生活质量,因此对细菌菌落总数的卫生标准有着严格的要求。
根据《食品安全国家标准食品微生物检验通则》(GB4789.2-2016)的规定,细菌菌落总数的卫生标准如下:1. 食品中细菌菌落总数的卫生标准。
一般食品,不超过10^5CFU/g。
低温食品,不超过10^4CFU/g。
罐头食品,不超过10^3CFU/g。
冷藏食品,不超过10^3CFU/g。
冷冻食品,不超过10^2CFU/g。
瓶装饮用水,不超过10^2CFU/mL。
桶装饮用水,不超过10^3CFU/mL。
2. 饮用水中细菌菌落总数的卫生标准。
自来水,不超过100CFU/mL。
瓶装饮用水,不超过100CFU/mL。
桶装饮用水,不超过100CFU/mL。
3. 医疗器械和环境空气中细菌菌落总数的卫生标准。
医疗器械,不超过100CFU/器械。
空气中,不超过100CFU/m³。
以上标准是针对不同场所、不同物品的细菌菌落总数制定的,旨在保障人们的健康和安全。
超过标准的细菌菌落总数可能导致食品变质、感染疾病等严重后果,因此严格执行卫生标准是十分必要的。
为了保证细菌菌落总数符合卫生标准,需要采取以下措施:1. 加强食品生产过程中的卫生管理,包括生产场所、设备、人员的卫生要求,确保生产过程不受细菌污染。
2. 严格控制食品的储存和运输温度,避免细菌在适宜的温度下繁殖。
3. 加强饮用水的卫生管理,包括水源的保护、水质的监测和处理等,确保饮用水符合卫生标准。
4. 定期对医疗器械和环境空气进行卫生检测和消毒,保证医疗器械和环境空气的卫生状况符合标准。
细菌菌落总数的卫生标准是保障公众健康的重要依据,只有严格执行标准要求,才能有效预防细菌污染带来的食品安全问题和疾病传播。


食品菌落总数检测标准食品安全一直是人们关注的焦点,而食品中的菌落总数是评价食品卫生质量的重要指标之一。
菌落总数是指在一定条件下,菌落在寄主(通常是琼脂培养基)上生长并形成可见菌落的数量。
食品中的菌落总数一般反映了食品是否受到了污染,以及食品是否在生产、加工、储存和运输过程中得到了适当的处理和保护。
根据《食品安全国家标准食品微生物学检验菌落总数的测定 GB 4789.2-2010》,食品中的菌落总数检测应该遵循以下步骤和标准:1. 样品的准备。
在进行菌落总数检测之前,首先需要准备好样品。
样品的准备应该符合相应的标准,避免样品受到二次污染或者样品本身就存在菌落过多的情况。
2. 菌落总数的测定方法。
菌落总数的测定方法一般采用平板计数法。
具体操作包括在琼脂培养基上平铺待测样品,然后在适当的温度下培养一定时间,再进行菌落的计数。
在进行菌落总数检测时,需要注意培养基的选择、温度的控制、培养时间等因素,以保证检测结果的准确性。
3. 结果的判定。
根据国家标准,食品中的菌落总数应该符合相应的标准要求。
一般来说,菌落总数超过一定的标准值就属于不合格。
对于不同类型的食品,其菌落总数的标准值也有所不同。
因此,在进行菌落总数检测时,需要参照相应的标准进行判定。
4. 结果的记录和报告。
检测结果应该及时记录并形成检测报告。
检测报告应包括样品的信息、检测方法、检测结果以及判定结果等内容。
检测报告应该保存一定的时间,并且在需要时能够提供给相关部门或者客户查阅。
总之,食品中的菌落总数检测是保障食品安全的重要环节,严格按照国家标准进行检测是确保食品质量的关键。
只有加强对食品菌落总数的检测,才能更好地保障人们的饮食安全,促进食品行业的健康发展。
菌落总数的测定一、菌落总数介绍:菌落是指细菌在固体培养基上生长繁殖而形成的能被肉眼识别的生长物,它是由数以万计相同的细菌集合而成。
当样品被稀释到一定程度,与培养基混合,在一定培养条件下,每个能够生长繁殖的细菌细胞都可以在平板上形成一个可见的菌落。
菌落总数就是指在一定条件下(如需氧情况、营养条件、pH、培养温度和时间等)每克(每毫升)检样所生长出来的细菌菌落总数。
按国家标准方法规定,即在需氧情况下,37℃培养48h,能在普通营养琼脂平板上生长的细菌菌落总数,所以厌氧或微需氧菌、有特殊营养要求的以及非嗜中温的细菌,由于现有条件不能满足其生理需求,故难以繁殖生长。
因此菌落总数并不表示实际中的所有细菌总数,菌落总数并不能区分其中细菌的种类,所以有时被称为杂菌数,需氧菌数等。
菌落总数测定是用来判定食品被细菌污染的程度及卫生质量,它反映食品在生产过程中是否符合卫生要求,以便对被检样品做出适当的卫生学评价。
菌落总数的多少在一定程度上标志着食品卫生质量的优劣。
二、检验方法菌落总数的测定,一般将被检样品制成几个不同的10倍递增稀释液,然后从每个稀释液中分别取出1mL置于灭菌平皿中与营养琼脂培养基混合,在一定温度下,培养一定时间后(一般为48小时),记录每个平皿中形成的菌落数量,依据稀释倍数,计算出每克(或每ml)原始样品中所含细菌菌落总数。
基本操作一般包括:样品的稀释--倾注平皿--培养48小时--计数报告。
国内外菌落总数测定方法基本一致,从检样处理、稀释、倾注平皿到计数报告无何明显不同,只是在某些具体要求方面稍有差别,如有的国家在样品稀释和倾注培养进,对吸管内液体的流速,稀释液的振荡幅度、时间和次数以及放置时间等均作了比较具体的规定。
检验方法参见:GB4789.2-94《中华人民共和国国家标准食品卫生微生物学检验菌落总数测定》SN0168-92《中华人民共和国进出口商品检验行业标准出口食品菌落计数》三、说明(一)样品的处理和稀释:1.操作方法:以无菌操作取检样25g(或25ml),放于225mL灭菌生理盐水或其他稀释液的灭菌玻璃瓶内(瓶内预置适当数量的玻璃珠)或灭菌乳钵内,经充分振要或研磨制成1:10的均匀稀释液。
GB4789.2对检验含芦荟成分保健食品菌落总数适用性的探讨摘要】目的探讨GB4789.2对含芦荟保健食品菌落总数的适用性。
方法以大肠埃希菌、金黄色葡萄球菌、枯草芽孢杆菌为代表菌株,计算用GB4789.2方法各菌的回收率,并建立最适用检验含芦荟保健食品菌落总数的方法。
结果含芦荟保健食品对金黄色葡萄球菌及枯草芽孢杆菌有抑制作用,用GB4789.2方法检验不能真实反映样品污染情况,改用薄膜过滤法则可取得较为满意的结果。
【关键词】芦荟保健食品 GB4789.2 菌落总数芦荟是一种可食、药两用的植物,广泛应用于保健饮料和食品、化妆品中。
保健(功能)食品通用标准GB16740-1997明确规定:保健食品菌落总数按GB4789.2规定的方法检验。
日常检验工作中我们发现,由于GB4789.2没有考虑样品自带干扰因素对微生物限度检查结果的影响,含芦荟成分的保健食品用GB4789.2的方法去检查菌落总数时会出现一些异常结果,本文主要探讨GB4789.2检验含芦荟保健食品菌落总数的适用性。
?1 材料与仪器1.1 培养基与试剂培养基:营养肉汤培养基(来源:北京三药;批号:090225);改良马丁培养基(来源:广东环凯;批号:201011031);改良马丁琼脂斜面培养基(来源:北京三药;批号:0912282);平板计数琼脂(来源:北京陆桥;批号:0905153);孟加拉红培养基(来源:广东环凯;批号:01009251)。
1%TTC、PH7.0无菌氯化钠-蛋白胨冲洗液、0.9%无菌氯化钠溶液(自配)。
1.2 菌种大肠埃希菌(Escherichiacoli)[CMCC(B)44102]、金黄色葡萄球菌(Staphylococcus aureus)[CMCC(B)26003]、枯草芽孢杆菌(Bacillus subtilis)[CMCC(B)63501]、白色念珠菌(Canidia Albicans)[CMCC(F)98001]、黑曲霉(Aspergillus niger)[CMCC(F)98003]。
菌落总数测定GB/T 4789.2—19941主题内容与适用范围本标准规定了食品中菌落总数的测定方法。
本标准适用于食品中菌落总数的测定。
2术语菌落总数是指食品检样经过处理,在一定条件下培养后(如培基成分、培养温度和时间、pH、需氧性质等),所得1mL(g)检样中所含菌落的总数。
本方法规定的培养条件下所得结果,只包括一群在营养琼脂上生长发育的嗜中温性需氧的菌落总数。
菌落总数主要作为判定食品被污染程度的标志,也可以应用这一方法观察细菌在食品中繁殖的动态,以便对被检样品进行卫生学评价时提供依据。
3引用标准GB 4789.28食品卫生微生物学检验染色法、培养基和试剂4设备和材料4.1温箱:36±1℃。
4.2冰箱:0~4℃。
4.3恒温水浴:46±1℃。
4.4天平。
4.5电炉4.6吸管。
4.7广口瓶或三角瓶:容量为500mL。
4.8玻璃珠:直径约5mm。
4.9平皿:直径为90mm。
4.10试管。
4.11放大镜。
4.12菌落计数器。
4.13酒精灯。
4.14均质器或乳钵。
4.15试管架。
4.16灭菌刀或剪子。
4.17灭菌镊子。
5培养基和试剂5.1营养琼脂培养基:按GB 4789.28中4.7规定。
5.2磷酸盐缓冲稀释液:按GB 4789.28中3.22规定。
5.3生理盐水。
5.475%乙醇。
6检验程序菌落总数的检验程序如下。
(图略)7操作步骤7.1检样稀释及培养7.1.1以无菌操作,将检样25g(或mL)剪碎放于含有225mL灭菌生理盐水或其他稀释液的灭菌玻璃瓶内(瓶内预置适当数量的玻璃珠)或灭菌乳钵内,经充分振摇或研磨做成1∶10的均匀稀释液。
固体检样在加入稀释液后,最好置均质器中以8000~10 000r/min的速度处理1min,做成1∶10的均匀稀释液。
7.1.2用1mL灭菌吸管吸取1∶10稀释液1mL,沿管壁徐徐注入含有9mL灭菌生理盐水或其他稀释液的试管内(注意吸管尖端不要触及管内稀释液),振摇试管,混合均匀,做成1∶100的稀释液。
中华人民共和国国家标准
食品卫生微生物学检验 GB 4789.2-94
菌落总数测定代替 GB 4789.2-84
Microbiological examination of food hygiene Detection
of aerobic bacterial count
───────────────────────────────────────1 主题内容与适用范围
本标准规定了食品中菌落总数的测定方法。
本标准适用于食品中菌落总数的测定。
2 术语
菌落总数是指食品检样经过处理,在一定条件下培养后(如培基成分、培养温度和时间、pH、需氧性质等),所得1mL(g)检样中所含菌落的总数。
本方法规定的培养条件下所得结果,只包括一群在营养琼脂上生长发育的嗜中温性需氧的菌落总数。
菌落总数主要作为判定食品被污染程度的标志,也可以应用这一方法观察细菌在食
品中繁殖的动态,以便对被检样品进行卫生学评价时提供依据。
3 引用标准
GB 4789.28 食品卫生微生物学检验染色法、培养基和试剂
4 设备和材料
4.1 温箱:36±1℃。
4.2 冰箱:0~4℃。
4.3 恒温水浴:46±1℃。
4.4 天平。
4.5 电炉。
4.6 吸管。
4.7 广口瓶或三角瓶:容量为500mL。
4.8 玻璃珠:直径约5mm。
4.9 平皿:直径为90mm。
4.10 试管。
4.11 放大镜。
4.12 菌落计数器。
4.13 酒精灯。
4.14 均质器或乳钵。
4.15 试管架。
4.16 灭菌刀或剪子。
4.17 灭菌镊子。
5 培养基和试剂
5.1 营养琼脂培养基:按GB 4789.28中4.7规定。
5.2 磷酸盐缓冲稀释液:按GB 4789.28中3.22规定。
5.3 生理盐水。
5.4 75%乙醇。
6 检验程序
菌落总数的检验程序如下。
┌─────┐
│检样│
└─────┘
↓
┌─────────────┐
│做成几个适当倍数的稀释液│
└─────────────┘
↓
┌──────────────┐
│选择2~3个适宜稀释度│
│各以1mL分别加入灭菌平皿内│
└──────────────┘
↓
┌─────────────┐
│每皿内加入适量营养琼脂│
└─────────────┘
36±1℃↓48±2h
┌─────┐
│菌落计数│
└─────┘
↓
┌──────┐
│报告│
└──────┘
7 操作步骤
7.1 检样稀释及培养
7.1.1 以无菌操作,将检样25g(或mL)剪碎放于含有225mL灭菌生理盐水或其他稀释液的灭菌玻璃瓶内(瓶内预置适当数量的玻璃珠)或灭菌乳钵内,经充分振摇或研磨做成1∶10
的均匀稀释液。
固体检样在加入稀释液后,最好置均质器中以8 000~10 000r/min的速度处理1min,
做成1∶10的均匀稀释液。
7.1.2 用1mL灭菌吸管吸取1∶10稀释液1mL,沿管壁徐徐注入含有9mL灭菌生理盐水或其
他稀释液的试管内(注意吸管尖端不要触及管内稀释液),振摇试管,混合均匀,做成1∶10
0的稀释液。
7.1.3 另取1mL灭菌吸管,按上条操作顺序,做10倍递增稀释液,如此每递增稀释一次,
即换用1支1mL灭菌吸管。
7.1.4 根据食品卫生标准要求或对标本污染情况的估计,选择2~3个适宜稀释度,分别
在做10倍递增稀释的同时,即以吸取该稀释度的吸管移1mL稀释液于灭菌平皿内,每个稀释度做两个平皿。
7.1.5 稀释液移入平皿后,应及时将凉至46℃营养琼脂培养基(可放置于46±1℃水浴保温)注入平皿约15mL,并转动平皿使混合均匀。
同时将营养琼脂培养基倾入加有1mL稀释液的灭菌平皿内作空白对照。
7.1.6 待琼脂凝固后,翻转平板,置36±1℃温箱内培养48±2h。
7.2 菌落计数方法
做平板菌落计数时,可用肉眼观查,必要时用放大镜检查,以防遗漏。
在记下各平板
的菌落数后,求出同稀释度的各平板平均菌落总数。
7.3 菌落计数的报告
7.3.1 平板菌落数的选择
选取菌落数在30~300之间的平板作为菌落总数测定标准。
一个稀释度使用两个平板,应采用两个平板平均数,其中一个平板有较大片状菌落生长时,则不宜采用,而应以
无片状菌落生长的平板作为该稀释度的菌落数,若片状菌落不到平板的一半,而其余一
半中菌落分布又很均匀,即可计算半个平板后乘2以代表全皿菌落数。
平皿内如有链状
菌落生长时(菌落之间无明显界线),若仅有一条链,可视为一个菌落;如果有不同来源
的几条链,则应将每条链作为一个菌落计。
7.3.2 稀释度的选择
7.3.2.1 应选择平均菌落数在30~300之间的稀释度,乘以稀释倍数报告之(见表中例1)。
7.3.2.2 若有两个稀释度,其生长的菌落数均在30~300之间,则视两者之比如何来决定。
若其比值小于或等于2,应报告其平均数;若大于2则报告其中较小的数字(见表中例2及3)。
7.3.2.3 若所有稀释度的平均菌落数均大于300,则应按稀释度最高的平均菌落数乘以
释稀倍数报告之(见表中例4)。
7.3.2.4 若所有稀释度的平均菌落数均小于30,则应按稀释度最低的平均菌落数乘以稀
释倍数报告之(见表中例5)。
7.3.2.5 若所有稀释度均无菌落生长,则以小于1乘以最低稀释倍数报告之(见表中例6)。
7.3.2.6 若所有稀释度的平均菌落数均不在30~300之间,其中一部分大于300或小于30 时,则以最接近30或300的平均菌落数乘以稀释倍数报告之(见表中例7)。
7.3.3 菌落数的报告
菌落数在100以内时,按其实有数报告,大于100时,采用二位有效数字,在二位有效
数字后面的数值,以四舍五入方法计算。
为了缩短数字后面的零数,也可用10的指数来
表示(见表中“报告方式”栏)。
稀释度选择及菌落数报告方式
──┬─────────────┬──────┬────┬─────────│稀释液及菌落数││菌落总数│报告方式
例次├────┬────┬───┤两稀释液之比│个/g或mL│个/g或mL │ 10-1 │ 10-2 │ 10-3 │││
──┼────┼────┼───┼──────┼────┼─────────
1 │多不可计│ 164 │ 20 │- │ 16 400 │16 000或1.6×10**4
2 │多不可计│ 295 │ 46 │ 1.6 │ 37 750 │
3 8000或3.8×10**4
3 │多不可计│ 271 │ 60 │ 2.2 │ 27 100 │27 000或2.7×10**4
4 │多不可计│多不可计│ 313 │- │ 313 000│31 000或3.1×10**5
5 │27 │11 │ 5 │- │ 270 │270或2.7×10**2
6 │0 │0 │0 │- │<1×10│<10
7 │多不可计│ 305 │ 12 │- │ 30 500│31 000或3.1×10**4 ──┴────┴────┴───┴──────┴────┴─────────
──────────
附加说明:
本标准由卫生部卫生监督司提出。
本标准由卫生部食品卫生监督检验所负责起草。
本标准主要起草人刘宏道。
本标准由卫生部委托技术归口单位卫生部食品卫生监督检验所负责解释。
───────────────────────────────────────中华人民共和国卫生部1994-03-18批准 1994-09-01实施。